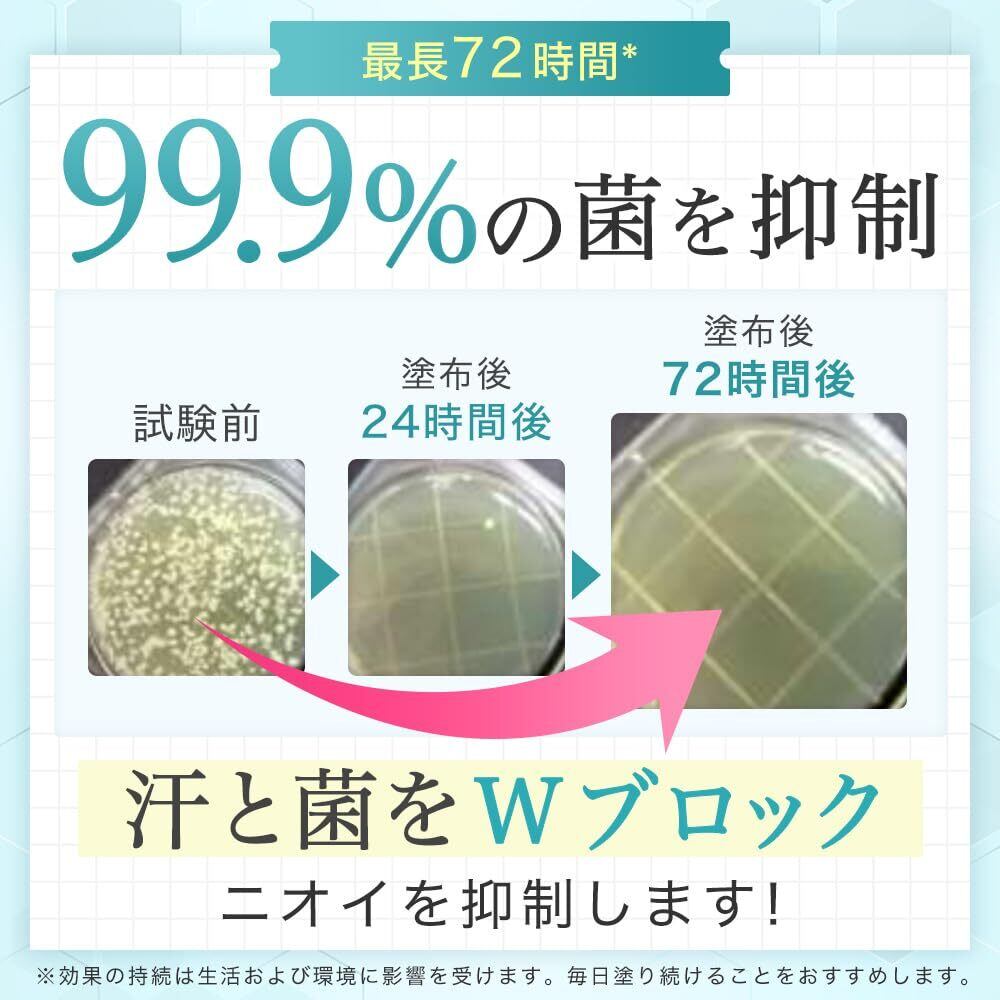

・翌月にまとめてお支払い可能
・手数料無料(口座振替の場合)
・アプリでご利用金額を確認できて安心

¥2,886 税込
なら 手数料無料の 翌月払いでOK
この商品は送料無料です。
ご覧いただきありがとうございます。
当店では他サイトにも商品を販売しているため
まれに売り切れや取り寄せ中となる場合がございますがご了承ください。
サイズ・カラー等のバリエーションはメッセージにて在庫をご確認のうえご購入お願い致します。
【商品名】
TESARAN テサランエア 制汗剤 デオドラント ワキガ わきがクリーム 脇汗 汗 脇 足 足の匂い消 消臭 靴 敏感肌 こども 医薬部外品 30g
【商品説明】
【ノンステロイド処方】ステロイドは炎症やアレルギー反応を抑える効果を持つ化学物質です。長期の仕様、乱用が副作用リスクを高めるため、テサランエアは医薬部外品でお子様にも安心のノンステロイド処方です。検査機関で徹底した検査を実施しており、100%お子様のために設計した商品です。
【99.9%の菌を抑制】クリームを塗布後、最長72時間ニオイのもとになる汗と菌をWブロック!※効果の持続は生活および環境に影響を受けます。毎日塗り続けることをおすすめします。
【汗のニオイを徹底ブロック】W有効成分で汗と菌をブロック!成長期の汗とニオイもさらさらスッキリ!※有効成分のクロルヒドロキシアルミニウムとイソプロピルメチルフェノールを配合。※効果には個人差また時期によって変化する場合がございます。
【こんな方に選ばれています】部活動でのニオイが心配・服の汗ジミが気になる・体臭が不安・汗やニオイの悩みに対してアドバイスがわからない。子供の悩みや不安に寄り添う親御様の声から生まれた商品です。
ブランド TESARAN(テサラン)
商品の形状 クリーム
香り ほのかに香るハーブティーの香り
素材タイプフリー 石油系界面活性剤・鉱物油フリー, 紫外線吸収剤フリー, タルクフリー, 安息香酸Na・動物性原料フリー, 合成着色料・合成香料(精油使用)フリー
特徴 医薬部外品(ノンステロイド処方), 汗臭 汗ジミ 脇汗対策
表示を増やす
最後までご覧いただきありがとうございました。
送料・配送方法について
お支払い方法について